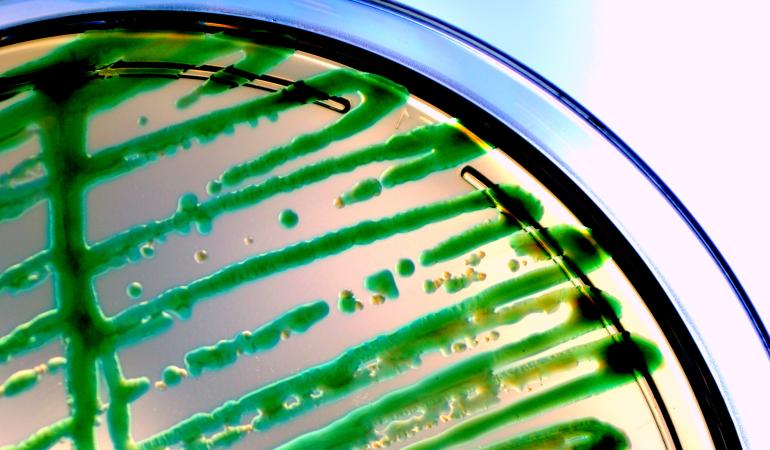

Het knelpunt ‘Zelfstandige leesbaarheid van ggo-dossiers’ is opgelost en de criteria voor het gebruik en aanleveren van informatie ten behoeve van het uitvoeren van een risicobeoordeling is beschikbaar op onze website.
Het knelpunt
In de huidige uitvoeringspraktijk is het uitgangspunt dat ieder dossier volledig zelfstandig leesbaar moet zijn en dat alle relevante informatie onderdeel moet uitmaken van het dossier. Dit heeft geleid tot administratieve lasten doordat u informatie bij gerelateerde aanvragen steeds opnieuw moest aanleveren.
De oplossing
Tijdens het project 'Oplossen knelpunten Besluit ggo2013' is uitgewerkt onder welke condities het voor u mogelijk is om naar eerder aangeleverde informatie of openbaar beschikbare informatie te kunnen verwijzen. Er zijn criteria opgesteld voor de informatievereisten ten aanzien van gastheren, vectoren, donorsequenties en ggo’s. In de afgelopen maanden heeft een werkgroep de criteria verder ingevuld en verhelderd. De criteria geven u duidelijkheid welke informatie in welke vorm beschikbaar moet zijn en hoe u de informatie bij aanvragen of kennisgevingen moet aanleveren. U kunt het document 'Criteria voor het gebruik van informatie ten behoeve van het uitvoeren van een risicobeoordeling Ingeperkt Gebruik' vinden op onze website. Wij raden u aan dit document zorgvuldig door te lezen.
Nieuwe versie IG formulieren en handleiding
Wij willen u ook wijzen op een nieuwe versie van de ingeperkt gebruik formulieren II-k, II-v en III. Nieuw in deze versie is dat u, bij een wijziging op een dossier, in de activiteitentabel moet aangeven of u een bestaande activiteit wilt wijzigen of dat u de handelingen als een nieuwe activiteit aan het dossier wilt toevoegen. Daarnaast is de 'Handleiding voor het invullen en indienen van formulieren IG', die u kunt gebruiken bij het invullen en indienen van een aanvraag, verbeterd. U vindt de nieuwste versie van de formulieren en de handleiding onder ‘IG downloads’.
Download direct rapport knelpunt zelfstandige leesbaarheid ggo-dossiers
170629 Rapport knelpunt zelfstandige leesbaarheid ggo-dossiers